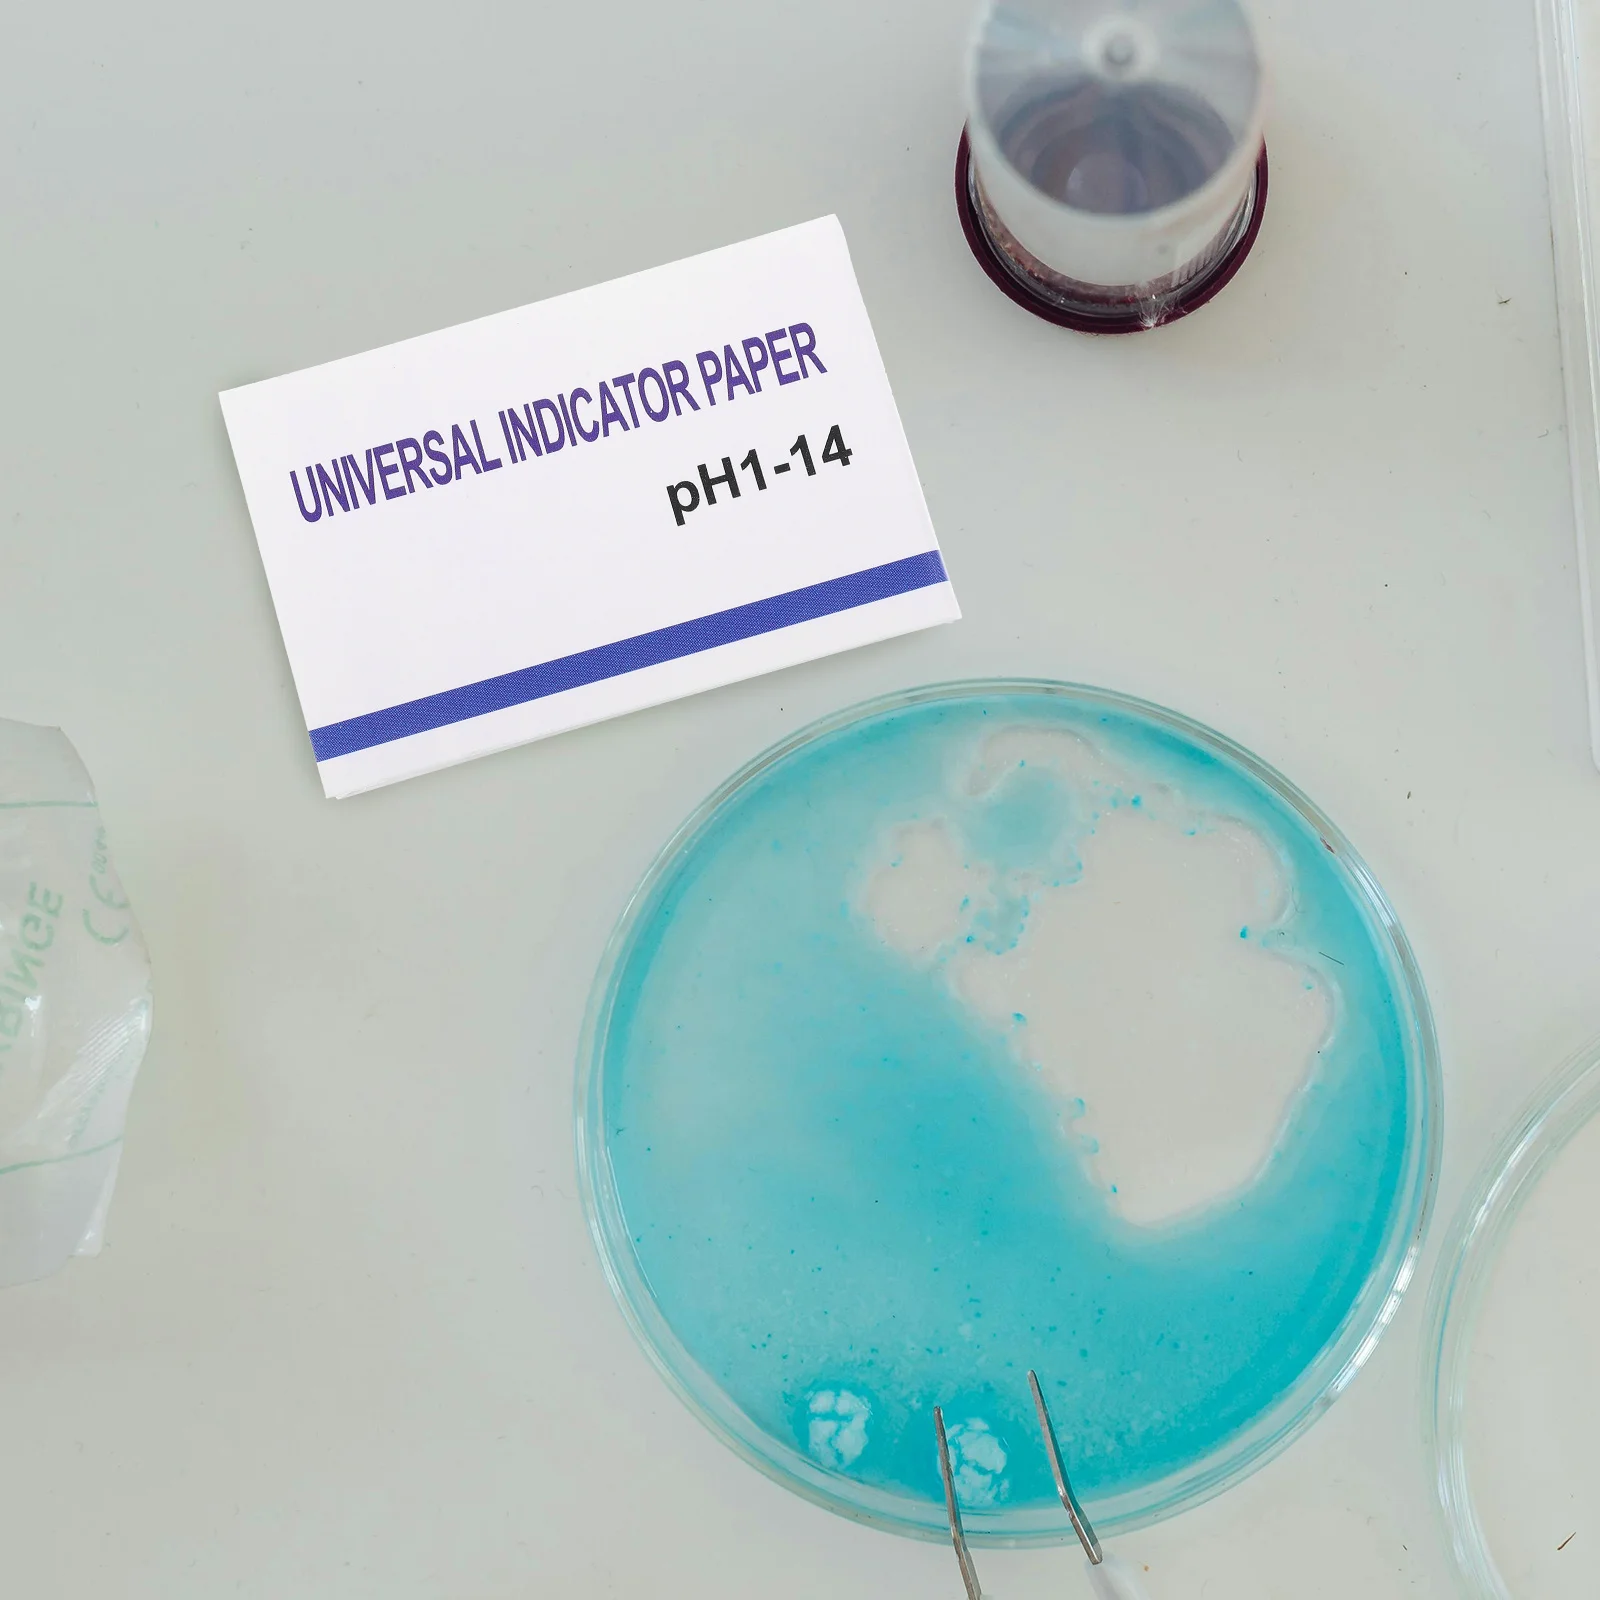
thumb

80Pcs PH Test Strips Professional Portable Precision Testing Papers for Water Liquid PH Level Test Testing Paper
Price history chart & currency exchange rate
Customers also viewed

$26.26
12V 110db OOGA Air Horn Antique Vintage Classic Old Style for Car / Motorcycle / Truck with Button, Wiring Harnesses Kit
aliexpress.ru
$10.97
Get the elf outta here - funny quirky Christmas Apron Kitchen Accessories 2022 Chef jacket men Apron
aliexpress.ru
$285.00
FHD 1080P 13,3 14 15,1 15,4 15,6 17,3 18,5 19 19,5 21,5 23 24 дюймов ЖК-дисплей компьютерный экран в негерметичном корпусе ЖК-монитор
aliexpress.ru
$98.60
Автомобильный Компрессор кондиционера для Chrysler Town и Country Dodge Grand Caravan для Volkswagen Routan 3.8L 55111417 55111417AC 55111417AD
aliexpress.com
$104.20
Милый костюм с расклешенными укороченными брюками, летний костюм из двух предметов в австралийском европейском и американском стиле, новинка 2024 года, 2024
aliexpress.com
$5.88
JEXXI 18 дюймов S90 серебряное Драгоценное Ожерелье Плоский бордюр цепочка на шею S90 серебряные цепочки наборы для ухода за кожей
aliexpress.ru
$24.56
Женский комплект из двух предметов, Привлекательный Топ с глубоким V-образным вырезом и перекрестной завязкой и облегающее боди, искусствен...
aliexpress.ru
$40.93
Африканская кружевная ткань с блестками 2022, высококачественное кружево, Нигерия, тюль, кружевная ткань, французское Сетчатое кружевное платье для невесты J4051
aliexpress.ru
$85.65
Для модификации ОЗУ автомобиля электронный насос Электронный Топливный насос 5145594AA RL145594AA 7548M E7270M
aliexpress.ru
$22.69
Бытовое лазерное устройство для удаления волос, Женская бритва, портативное мини-устройство для удаления волос, устройство для удаления волос на лице
aliexpress.ru
$21.76
Для LP156WF6 (СП)/SP 1920x1080 15,6 "Micro 2 HDMI совместимых с ЖК-дисплей EDP плата контроллера монитора ЖК-дисплей Дисплей Панель светодиодный мини 5V питания
aliexpress.ru
$41.32
14inches short afro kinky curly wig natural synthetic front lace wigs for women black /brown/burgundy color hair heat resistant
dhgate.com
$26.76
100% stitched duke blue devils ncaa college basketball jersey cam 2 reddish rj 5 barrett blue white black jerseys
dhgate.com
$27.98
Girls Pajama Summer Night Dress for Toddlers Soft Cotton Lace Bowknot Nightgown Princess Dress Sleepwear
aliexpress.com
$21.60
Women's Bathrobe Cotton Pajamas Winter Robe Pyjamas Bath Towel Spring and Warm Bath Suit Badjas Female Sleepwear Robes
aliexpress.com
$20.66
Golf Rotating Swing Trainer Golf Swing Posture Auxiliary Improve Posture Swing To Trainer Speed Correct Correctter -40
aliexpress.com
$6.56
2021 New Autumn Leggings Girl Star Leggings Baby Soft Lace Knitted Pant Kids Cotton Trousers
aliexpress.com
$9.72
Майка борцовка спортивная мужская MUAY THAI MT21SUB Материал: Полиэстер. Цвет: Черный. Размер: L (50-52)
rozetka.com.ua
$18.29
23Pcs Washable HEPA Filter Main Brushes Side Brushes Mop Parts for Xiaomi Roborock S5 Max S6 Vacuum Cleaner Accessories
aliexpress.com
$0.55
mask 3-ply mouth for pmsfu disposable shipping for fa pollution dustproof and safety mask home air work er bfrnq
dhgate.com
$1.31
silk black dust mouth fa thin white kiupv fy9041 kids mask fashion i mask red celebrity masks children fa proof breathable lprkj gwbe
dhgate.com
$49.68
Original Nike Air Max TailWind IV TN-4 air cushion men's running shoes size 40-46
aliexpress.com
$37.27
2018 Ultra 3.0 4.0 Triple Black White oreo Multicolor CNY Men Women Running Shoes Breath Trainer Runner Sports Sneakers US 5-11
dhgate.com
$29.71
Brand Men Light weight Casual Shoes Men Sneaker Shoes Flats Knitted Fly weaving Breathable Socks Flats Unisex KK-75
dhgate.com
$76.98
With box Travis x 4s 2018 Houston Blue Black mens Basketball Shoes Cactus Jack 308497-406 For Men Scotts Trainers sports sneakers size 7-13
dhgate.com
$30.22
18FW Speedhunter Sweatshirt for Men Hoodies Women Rock OS Style Pullover Letter Print Tees Round Neck Long Sleeve Shirt Streetwear Black
dhgate.com$19.36
Women Casual Women Backpack PU Leather School Backpack For Teenager Girls Travel Backpack Vintage Solid Shoulder Bags
aliexpress.com$8.46
interruptor XKC-Y26A-PNP Liquid Level Sensor 5~12V PNP Output Output Interface IP65 Capacitive <br> micro switch
aliexpress.com$26.92
Women Tracksuits Exercise Outfits Sets Fitness Yoga Leggings Sportswear Warm Suits Female Sports Pants Long Sleeve Tops T Shirts
aliexpress.com
$8.71
Природный нефритовый горячий камень энергетический спа-камень для Гуа-Ша массаж антицеллюлитного камня Guasha Инструмент для массажа
aliexpress.ru
$3.23
Резиновый ремень ГРМ 3GT, длина 171 174 177 180 183 186 189 192 195 198 201 204 мм Ширина 6/9/10/15/20 мм Синхронный приводной ремень
aliexpress.ru

/snikerci-sprandi-wp07-gva-1-chornii-5905588397908.jpg)







